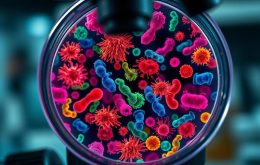

Melanina – funkcje, rodzaje i jej rola w ochronie skóry
Melanina to fascynujący barwnik, który nie tylko nadaje kolor naszym włosom, skórze i oczom, ale także odgrywa kluczową rolę w ochronie naszego organizmu przed szkodliwym promieniowaniem UV. Odpowiada za różnice w pigmentacji, a jej synteza zachodzi w melanocytach, które reagują na ekspozycję na słońce, zwiększając produkcję tego cennego pigmentu. Istnieją …
Pompki z gumą: technika, korzyści i wskazówki dla skutecznego treningu
Pompki z gumą to dynamiczne i wszechstronne ćwiczenie, które zyskuje coraz większą popularność wśród entuzjastów fitnessu. Dzięki zastosowaniu gum oporowych, trening staje się nie tylko bardziej efektywny, ale również dostępny dla osób o różnym poziomie zaawansowania. To ćwiczenie angażuje kluczowe grupy mięśniowe, takie jak mięśnie klatki piersiowej, barków i tricepsów, …
Jak skutecznie radzić sobie z nadpotliwością stóp? Porady i metody
Pocenie się stóp to problem, z którym zmaga się około 3% populacji na całym świecie. Choć naturalna regulacja temperatury ciała, nadpotliwość stóp potrafi być uciążliwa, prowadząc do nieprzyjemnych zapachów i dyskomfortu. Przyczyn tego zjawiska jest wiele – od zaburzeń hormonalnych, przez otyłość, po różnorodne infekcje. W miarę jak zmiany stylu …
Przerwa między udami – jak ją osiągnąć za pomocą diety i ćwiczeń?
Przerwa między udami to temat, który zyskuje coraz większą popularność wśród osób dążących do osiągnięcia idealnej sylwetki. Wiele kobiet marzy o tej przestrzeni, postrzegając ją jako symbol atrakcyjności i zdrowego stylu życia. Jednak osiągnięcie tego efektu nie jest proste i zależy od wielu czynników, w tym genetyki, stylu życia oraz …
Ból kolana po wewnętrznej stronie – przyczyny, diagnostyka i leczenie
Ból kolana po wewnętrznej stronie to dolegliwość, która dotyka wielu osób, niezależnie od ich wieku czy poziomu aktywności fizycznej. Często jest to sygnał, że organizm wymaga uwagi, a przyczyny mogą być różnorodne — od urazów po zmiany zwyrodnieniowe. Dla sportowców, intensywne treningi mogą prowadzić do przeciążeń, które skutkują dyskomfortem, podczas …
Bieganie w czasie przeziębienia – zasady i ryzyka do rozważenia
Bieganie to jedna z najpopularniejszych form aktywności fizycznej, która wielu osobom towarzyszy przez cały rok. Jednak, co się dzieje, gdy przychodzi sezon przeziębień? Czy warto kontynuować treningi, gdy odczuwamy łagodne objawy choroby, czy lepiej dać sobie czas na regenerację? Zasada szyi wskazuje, że nie każdy katar czy ból gardła musi …
Dieta wg grupy krwi – co warto wiedzieć o jej zasadach i ryzykach?
Dieta według grupy krwi zyskuje na popularności jako sposób na poprawę zdrowia i samopoczucia. Opiera się na fascynującej teorii ewolucji, sugerującej, że różne grupy krwi wykształciły się w odpowiedzi na zmieniające się warunki środowiskowe, co z kolei wpływa na nasze preferencje żywieniowe. Zwolennicy tej diety twierdzą, że dostosowanie diety do …
Najgroźniejsze choroby bakteryjne i ich wpływ na zdrowie ludzkości
Jakie są najgroźniejsze choroby bakteryjne i ich wpływ na zdrowie? W obliczu rosnącego problemu oporności na antybiotyki, bakterie stają się jednymi z największych zagrożeń dla zdrowia publicznego. Co roku na całym świecie około 700 tysięcy osób umiera z powodu infekcji wywołanych przez te mikroorganizmy, a prognozy wskazują, że do 2050 …
Kojące kosmetyki: jak działają i jakie składniki wybierać?
Kojące kosmetyki stanowią odpowiedź na potrzeby osób z wrażliwą skórą, która często zmaga się z podrażnieniami i nadreaktywnością. Dzięki zastosowaniu starannie dobranych surowców łagodzących, takich jak alantoina, pantenol czy ekstrakt z aloesu, te produkty nie tylko przynoszą ulgę, ale również wspierają regenerację skóry. W świecie, gdzie stres i zanieczyszczenia wpływają …
Plan odchudzania 20 kg: zasady, deficyt kaloryczny i dieta
Plan odchudzania, który ma na celu zrzucenie 20 kg, to ambitne, ale możliwe do osiągnięcia wyzwanie, które wymaga staranności i determinacji. Warto pamiętać, że skuteczna utrata wagi to nie tylko kwestia diety, ale również aktywności fizycznej oraz odpowiednich nawyków żywieniowych. Każda osoba ma swoje unikalne potrzeby i ograniczenia, dlatego kluczowe …
Fitness
Ostatnie wpisy
Najnowsze komentarze
Archiwa
- czerwiec 2026
- maj 2026
- kwiecień 2026
- marzec 2026
- luty 2026
- styczeń 2026
- grudzień 2025
- listopad 2025
- październik 2025
- wrzesień 2025
- sierpień 2025
- lipiec 2025
- czerwiec 2025
- maj 2025
- kwiecień 2025
- marzec 2025
- luty 2025
- styczeń 2025
- grudzień 2024
- listopad 2024
- październik 2024
- wrzesień 2024
- sierpień 2024
- lipiec 2024
- maj 2024
- kwiecień 2024
- marzec 2024
- luty 2024
- styczeń 2024
- grudzień 2023
- październik 2023
- sierpień 2023
- czerwiec 2023
- maj 2023
- luty 2023
- wrzesień 2022
- lipiec 2022
- czerwiec 2022
- kwiecień 2022
- sierpień 2021
- czerwiec 2021
- marzec 2021
- styczeń 2021
- grudzień 2020
- listopad 2020
- październik 2020
- wrzesień 2020
- sierpień 2020
- lipiec 2020
- czerwiec 2020
- maj 2020
- kwiecień 2020
- marzec 2020
- luty 2020
- styczeń 2020
- grudzień 2019
- sierpień 2019
- lipiec 2019
- czerwiec 2019
- marzec 2019
- luty 2019
- styczeń 2019
- grudzień 2018
- listopad 2018
- październik 2018
- wrzesień 2018
- sierpień 2018
- lipiec 2018
- czerwiec 2018
- maj 2018
- kwiecień 2018
- marzec 2018
- luty 2018
- styczeń 2018
- grudzień 2017
- listopad 2017
- październik 2017
- wrzesień 2017
- sierpień 2017
- lipiec 2017
- czerwiec 2017
- maj 2017
- kwiecień 2017
- marzec 2017
Categories
Przeczytaj
- Bieganie a zdrowie kręgosłupa: korzyści, zagrożenia i porady
- Wyposażenie gabinetu stomatologicznego w hurtowni TerraDent
- Rozciąganie gumy przed treningiem klatki piersiowej – dlaczego warto?
- Jak sprawdzić rozmiar kół w rowerze i dobrać odpowiednie opony?
- Przysiad sumo – jak prawidłowo go wykonać i jakie ma korzyści?